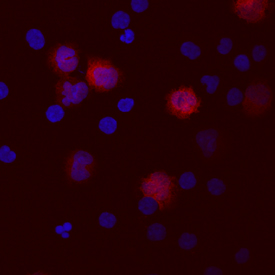
IL-1 beta/IL-1F2 antibody in Human PBMCs by Immunocytochemistry (ICC).

Human IL-1 beta/IL-1F2 Antibody
R&D Systems, part of Bio-Techne | Catalog # MAB201


Conjugate
Catalog #
Key Product Details
Validated by
Biological Validation
Species Reactivity
Validated:
Human
Cited:
Human, Mouse, Transgenic Mouse
Applications
Validated:
Western Blot, Neutralization, Intracellular Staining by Flow Cytometry, Immunocytochemistry, Simple Western, CyTOF-ready
Cited:
Immunohistochemistry-Paraffin, Western Blot, Neutralization, Flow Cytometry, Immunocytochemistry, ELISA Development, Mass Cytometry
Label
Unconjugated
Antibody Source
Monoclonal Mouse IgG1 Clone # 8516
Product Specifications
Immunogen
E. coli-derived recombinant human IL-1 beta/IL-1F2
aa 117-269
Accession # P01584
aa 117-269
Accession # P01584
Specificity
Detects human IL-1 beta/IL-1F2 in Western blots. Shows less than 5% cross-reactivity with recombinant mouse (rm) IL‑1 beta and rpIL‑1 beta and no cross-reactivity with rrIL‑1 beta, rmIL‑1 alpha, rhIL‑1ra, rmIL‑1ra, or rrIL‑1 alpha.
Clonality
Monoclonal
Host
Mouse
Isotype
IgG1
Endotoxin Level
<0.10 EU per 1 μg of the antibody by the LAL method.
Scientific Data Images for Human IL-1 beta/IL-1F2 Antibody
Detection of Human IL‑1 beta/IL‑1F2 by Western Blot.
Western blot shows lysates of THP-1 human acute monocytic leukemia cell line untreated (-) or treated (+) with 200 nM PMA for 24 hours and 10 µg/mL LPS and 3 hours. PVDF membrane was probed with 1 µg/mL of Mouse Anti-Human IL-1 beta/IL-1F2 Monoclonal Antibody (Catalog # MAB201) followed by HRP-conjugated Anti-Mouse IgG Secondary Antibody (Catalog # HAF018). A specific band was detected for IL-1 beta/IL-1F2 at approximately 36 kDa (as indicated). This experiment was conducted under reducing conditions and using Immunoblot Buffer Group 1.IL‑1 beta/IL‑1F2 in Human PBMCs.
IL-1 beta/IL-1F2 was detected in immersion fixed human peripheral blood mononuclear cells (PBMCs) using Human IL-1 beta/IL-1F2 Monoclonal Antibody (Catalog # MAB201) at 10 µg/mL for 3 hours at room temperature. Cells were stained using the NorthernLights™ 557-conjugated Anti-Mouse IgG Secondary Antibody (red; Catalog # NL007) and counterstained with DAPI (blue). View our protocol for Fluorescent ICC Staining of Non-adherent Cells.IL‑1 beta/IL‑1F2 in Human PBMCs.
IL-1 beta/IL-1F2 was detected in immersion fixed human peripheral blood mononuclear cells (PBMCs) treated with LPS and monensin using Human IL-1 beta/IL-1F2 Monoclonal Antibody (Catalog # MAB201) at 10 µg/mL for 3 hours at room temperature. Cells were stained using the NorthernLights™ 557-conjugated Anti-Mouse IgG Secondary Antibody (yellow; Catalog # NL007) and counterstained with DAPI (blue). View our protocol for Fluorescent ICC Staining of Non-adherent Cells.Applications for Human IL-1 beta/IL-1F2 Antibody
Application
Recommended Usage
CyTOF-ready
Ready to be labeled using established conjugation methods. No BSA or other carrier proteins that could interfere with conjugation.
Immunocytochemistry
8-25 µg/mL
Sample: Immersion fixed human peripheral blood mononuclear cells (PBMCs) stimulated with LPS, or with LPS and monensin
Sample: Immersion fixed human peripheral blood mononuclear cells (PBMCs) stimulated with LPS, or with LPS and monensin
Intracellular Staining by Flow Cytometry
2.5 µg/106 cells
Sample: Human peripheral blood mononuclear cells treated with LPS, fixed with paraformaldehyde, and permeabilized with saponin
Sample: Human peripheral blood mononuclear cells treated with LPS, fixed with paraformaldehyde, and permeabilized with saponin
Simple Western
10 µg/mL
Sample: TF‑1 human erythroleukemic cell line
Sample: TF‑1 human erythroleukemic cell line
Western Blot
1 µg/mL
Sample: THP‑1 human acute monocytic leukemia cell line treated with PMA and LPS
Sample: THP‑1 human acute monocytic leukemia cell line treated with PMA and LPS
Neutralization
Measured by its ability to neutralize IL‑1 beta/IL‑1F2-induced proliferation in the D10.G4.1 mouse helper T cell line. Symons, J.A. et al. (1987) in Lymphokines and Interferons, a Practical Approach. Clemens, M.J. et al. (eds): IRL Press. 272. The Neutralization Dose (ND50) is typically 0.001-0.003 µg/mL in the presence of 50 pg/mL Recombinant Human IL‑1 beta/IL‑1F2.
Reviewed Applications
Read 8 reviews rated 4.4 using MAB201 in the following applications:
Formulation, Preparation, and Storage
Purification
Protein A or G purified from hybridoma culture supernatant
Reconstitution
Reconstitute at 0.5 mg/mL in sterile PBS. For liquid material, refer to CoA for concentration.
Formulation
Lyophilized from a 0.2 μm filtered solution in PBS with Trehalose. *Small pack size (SP) is supplied either lyophilized or as a 0.2 µm filtered solution in PBS.
Shipping
Lyophilized product is shipped at ambient temperature. Liquid small pack size (-SP) is shipped with polar packs. Upon receipt, store immediately at the temperature recommended below.
Stability & Storage
Use a manual defrost freezer and avoid repeated freeze-thaw cycles.
- 12 months from date of receipt, -20 to -70 °C as supplied.
- 1 month, 2 to 8 °C under sterile conditions after reconstitution.
- 6 months, -20 to -70 °C under sterile conditions after reconstitution.
Background: IL-1 beta/IL-1F2
Long Name
Interleukin 1 beta
Alternate Names
IL-1b, IL-1F2, IL1 beta, IL1B
Entrez Gene IDs
Gene Symbol
IL1B
UniProt
Additional IL-1 beta/IL-1F2 Products
Product Documents for Human IL-1 beta/IL-1F2 Antibody
Product Specific Notices for Human IL-1 beta/IL-1F2 Antibody
For research use only
Loading...
Loading...
Loading...
Loading...
Loading...